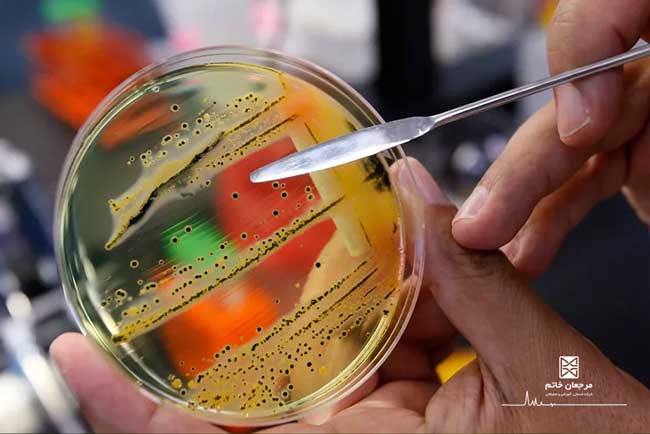

شفاآنلاین>سلامت>طبق گزارش سازمان جهانی بهداشت، سالمونلا باعث بیمار شدن میلیونها نفر و مرگ بیش از ۱۰۰ هزار نفر در سال در سراسر جهان میشود که تقریباً ۸۵ درصد آن به دلیل غذای آلوده است.
از آنجا که این باکتری تغییری در ظاهر، بو و حتی مزه مواد غذایی ایجاد نمیکند و از طرفی نسبت به آنتی بیوتیکها هم مقاوم است، چه در کشورهای در حال توسعه و چه در کشورهای توسعه یافته، مشکلات بزرگی را برای صنایع غذایی و سلامت انسانها ایجاد میکند.
ماری مالون در سال ۱۸۶۹ در ایرلند متولد شد و در سن ۱۵ سالگی به آمریکا مهاجرت کرده و به عنوان آشپز در منزل خانواده های ثروتمند شروع به کار کرد. در سال ۱۹۰۶ در یکی از این منازل، ۷ نفر بیمار شدند. صاحبخانه به دنبال بررسی علت این موضوع، فردی را استخدام کرد. او متوجه شد که ماری مالون در طول دوران کارش باعث بیمار شدن ۲۲ نفر و مرگ یک نفر در اثر تب حصبه شد.
ماری مالون سپس توسط پلیس بازداشت شده و پس از نمونه گیری و بررسی، باسیل حصبه (سالمونلا تیفی) در مدفوع او یافت شد. او بر اساس حکم مقامات بهداشتی در جزیره ای قرنطینه شد و به مدت دو سال، تقریباً اغلب نمونه های مدفوع او مثبت و حاوی باکتری بود. ماری مالون از اداره بهداشت شکایت کرد چرا که معتقد بود هیچ علائمی از بیماری در او وجود ندارد و خواستار آزادی شد. سرانجام در سال ۱۹۱۰ یک مأمور جدید بهداشت، ماری را به شرط اینکه دیگر به عنوان آشپز کار نکند، آزاد کرد.
در ژانویه ۱۹۱۵ بیمارستانی در منهتن دچار شیوع تب حصبه شد که ۲۵ نفر بیمار شده و دو نفر از آنها فوت شدند. بعد از بررسی، متوجه شدند که به تازگی یک آشپز به نام خانم براون استخدام شده است. خانم براون در حقیقت همان ماری مالون بود که با نام مستعار مشغول به کار شده بود. بعد از این جریان ماری مالون به مدت ۲۳ سال در جزیره ای قرنطینه شد و در همانجا درگذشت.

علائم شایع سالمونلا شامل تب، اسهال، گرفتگی معده و استفراغ، بعد از ۶ ساعت تا ۳ روز ظاهر شده و معمولاً طی ۷-۴ روزمنجر به مرگ فرد می شود. در صورت کم آبی شدید بدن علائمی مثل سرگیجه، تپش قلب، تیره شدن رنگ ادرار و خشکی لب و دهان مشاهده می شود.
بیماریهای نادری که ممکن است توسط سالمونلا ایجاد شود:
· بیماری آرتریت؛ واکنشی که علائم آن متورم شدن مفاصل مثل زانو، قوزک پا و انگشتان پا است.
· در کودکان و افراد با سیستم ایمنی پایین باعث مننژیت (بیماری التهاب پرده های محافظتی مغز)؛ که علائم آن شامل لرز، گرفتگی گردن، خواب آلودگی، استفراغ و ... است.
باکتری سالمونلا میتواند در مواد غذایی بخصوص مواد غذایی خام مانند گوشت، مرغ، تخم مرغ و سبزیجات وجود داشته باشد. باکتری هنگام تماس با مواد غذایی آلوده به دست چسبیده و از این طریق به مواد غذایی و سطوح غیرآلوده منتقل میشود. از طرفی، سالمونلا میتواند در روده حیوانات خانگی مانند لاک پشت، پرندگان، سگ و گربه وجود داشته باشد که از طریق مدفوع آن ها دفع شده و فلس، پر، مو و محیط زندگی آن ها را آلوده میکند.
بنابراین لمس حیوانات در گسترس سالمونلا در منزل شما، میتواند مؤثر باشد. سالمونلا بعد از ورود به بدن انسان ممکن است تا بیشتر از یکسال از طریق مدفوع دفع شود (مانند آشپز معروف ماری مالون) و چنانچه افراد ناقل، بهداشت فردی را بخصوص بعد از استفاده از سرویس بهداشتی، رعایت نکنند، بیماری گسترش پیدا خواهد کرد. البته حشرات ناقل مانند مگس و سوسکهای حمام نیز در انتقال آلودگی نقش دارند.
برای جلوگیری از گسترش آلودگی سالمونلا در منزل لازم است ۴ مرحله زیر را انجام دهید:
۱- تمیز کردن:
- دستهای خود را با آب گرم و صابون قبل و بعد از پخت غذا، بعد از استفاده از سرویس بهداشتی و لمس کردن حیوانات بشویید.
- وسایل آشپزخانه که با مواد غذایی در تماس هستند مانند چاقو و تخته برش را با محلول یک قاشق غذا خوری هیپوکلریت سدیم (وایتکس) در حدود ۴ لیتر آب، ضد عفونی و سپس بطور کامل آبکشی کنید.
- سبزیجات خام و میوه ها را قبل از مصرف بشویید و در صورت امکان، پوست میوه را کنده و در مورد سبزیجاتی مانند کلم و کاهو، برگهای بیرونی را جدا کنید.
۲- جداسازی:
- بدلیل اینکه احتمال آلودگی مواد غذایی بعد از پخت هم وجود دارد، جدا کردن مواد غذایی پخته از خام و انتقال آن ها به یخچال و گرم کردن آنها قبل از مصرف می تواند به ورود کمتر باکتری به بدن کمک کند.
- در صورت استفاده از تخته برش، از تخته جدا برای مواد غذایی خام و پخته استفاده کنید، چون به مرور زمان و بر اثر خط و خش ایجاد شده روی آن، منبع تجمع آلودگی سالمونلا می شوند.
- هرگز مواد غذایی پخته را در ظرفی که قبلاً در آن مواد غذایی خام گذاشته شده و تمیز شسته نشده، قرار ندهید.
۳- پختن:
- پخت کامل گوشت، مرغ، تخم مرغ و نوشیدن شیر پاستوریزه (دمای لازم برای پخت در وب سایت مرجعان خاتم در دسترس است).
۴- خنک نگه داشتن:
- دمای یخچال را روی ۴ درجه سانتی گراد یا پایین تر تنظیم کنید.
- هرگز مواد غذایی که زود فاسد میشوند مانند گوشت قرمز و مرغ را بیشتر از دو ساعت بیرون از یخچال قرار ندهید. البته در دماهای بالای ۳۲ درجه سانتی گراد، این مدت زمان باید به یک ساعت کاهش پیدا کند.
و در آخر دور نگهداشتن حشرات ناقل از محل طبخ غذا می تواند به کنترل این باکتری در منزل کمک کند.

آزمایشگاه مرجعان خاتم شرکت خصوصی دانش بنیانی است که بیش از ۲۰ سال از شروع فعالیت آن در حوزه سلامت مواد غذایی میگذرد. در حال حاضر خدمات آزمایشگاهی مرجعان خاتم در سه شعبه آزمایشگاه تهران، آزمایشگاه خرمشهر و آزمایشگاه بندر امام خمینی ارائه میشود.
در این آزمایشگاهها که تأییدیه سازمان ملی استاندارد، سازمان دامپزشکی کل کشور و سازمان غذا و داروی وزارت بهداشت را در اختیار دارد، خدمات گستردهای با دقت بالا و در کمترین زمان ممکن از طریق کارشناسان حرفهای و دستگاههای پیشرفته آزمایشگاهی، به متقاضیان و محققان ارائه می شود.
همچنین آزمایشگاه میکروبیولوژی مسئولیت ردیابی و شناسایی باکتریهای پاتوژن و شمارش برخی میکروارگانیسمها را در تمامی نمونههای واصله به آزمایشگاه را بر عهده دارد.
آزمایشگاه میکروبی مرجعان خاتم
قادر به انجام آزمون های میکروبی شامل شمارش کلی میکروارگانسیمها، شمارش و
شناسایی اشریشیاکلی، شناسایی سالمونلا در مواد غذایی، کلی فرم، کپک و
مخمر، انتروباکتریاسه، انتروکوک رودهای، کلوستریدیوم، باکتری های
اسیدلاکتیک مقاوم به اسید، شمارش پروبیوتیک در فرآورده های غذایی و
آشامیدنی با استفاده از دستورالعمل های ملی و بین المللی میباشد.خبر آنلاین